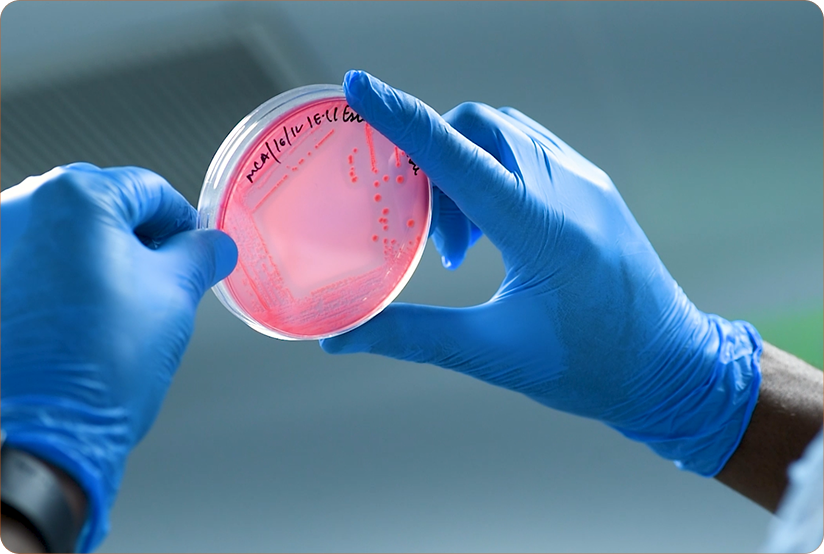

Our state-of-the-art 20,000-square-foot laboratory is the cornerstone of our innovation. Here, over 60 experts in agriculture, botany, microbiology, analytical sciences, and Ayurveda collaborate to reimagine traditional wellness for modern lifestyles. Our team delves deep into the cellular properties of active plant compounds, designing formulations that seamlessly integrate Ayurvedic herbs into everyday routines.
Through this fusion of ancient knowledge and modern science, Ayurveda Lifestyle delivers natural wellness solutions that are not only effective but also sustainable, embodying a perfect harmony between tradition and innovation.



Comprehensive Quality Assurance
-

Physicochemical Testing
Quality begins at the molecular level. Our rigorous physicochemical testing ensures that every batch meets the highest standards. We evaluate vital organoleptic properties such as aroma, color, texture, pH, specific gravity, and viscosity. Utilizing advanced techniques like High-Performance Liquid Chromatography (HPLC), we analyze bioactive ingredients and maintain purity profiles in line with pharmacopeial standards. This meticulous process guarantees batch-to-batch consistency and preserves the potency of our natural formulations, ensuring unparalleled efficacy and quality.
-

Microbiological Testing
Safety is at the heart of our operations. Each product undergoes thorough microbiological analysis in a cleanroom facility to detect and eliminate harmful microbial contaminants. Adhering to global methodologies (IS, ISO, USP, EP, IP, and others), we test for pathogens like Listeria monocytogenes, Salmonella sp., and E. coli, ensuring the safety of both raw materials and finished products. This stringent monitoring underscores our promise to deliver products that are not only effective but also safe and reliable.
-

Pesticides and Contaminants Analysis
Our commitment to purity extends to eliminating harmful contaminants. Using advanced technologies such as UPLC-MS/MS, GC-MS/MS, and ICP-M. We meticulously test for pesticide residues, mycotoxins, heavy metals, and other toxins. From raw ingredients to finished products, every step is monitored to ensure sustainability and consumer safety, making Ayurveda Lifestyle a benchmark for uncompromised quality.
Innovation Rooted in Tradition